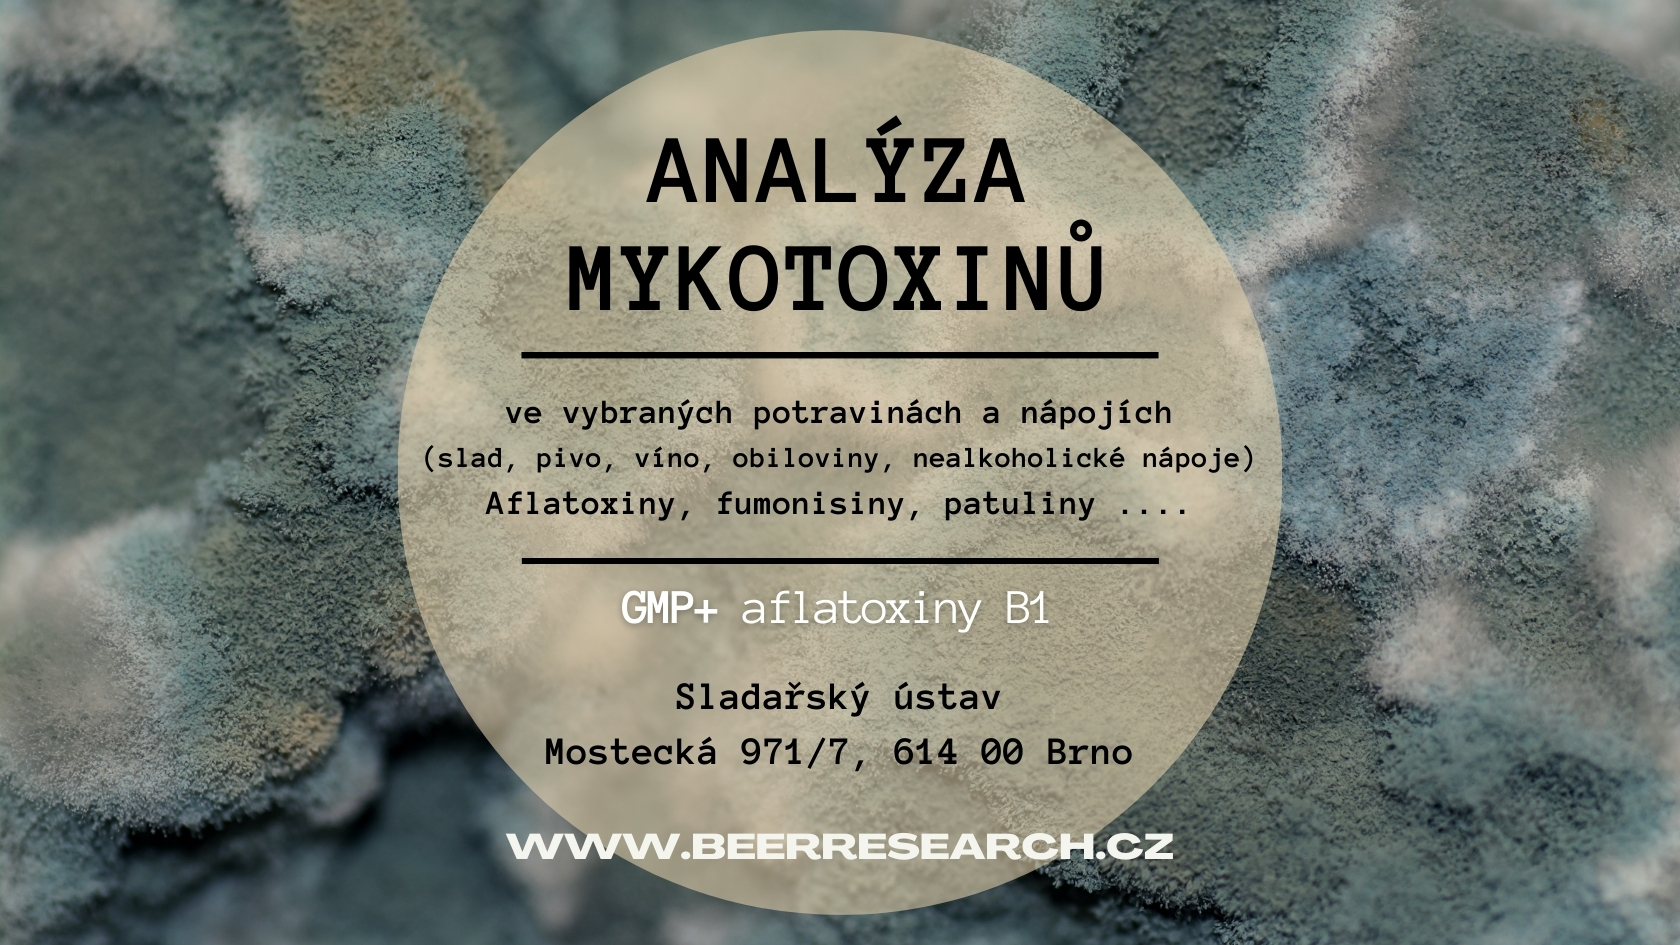
mykotoxiny, aflatoxiny, gmp+

Produkty
Doporučujeme
Vítejte v našem obchodě!
Výzkumný ústav pivovarský a sladařský (VÚPS)
Jediný výzkumný ústav v České republice, který se od roku 1887 soustavně věnuje pivovarsko-sladařské problematice.
Základní činností je výzkum, vývoj, inovace a zvyšování odborných znalostí široké veřejnosti.
Naši pracovníci ústavu se vedle výzkumu věnují i kontrole jakosti surovin a finálních výrobků. V laboratořích se na špičkových přístrojích provádí široká škála analýz (analytické, mikrobiologické a senzorické). Vlastníme špičkové technologické vybavení dvou experimentálních pivovarů, které umožňují provádět experimenty, pro ověřování či vývoj nových výrobků a technologických postupů.
Odborníci z výzkumného ústavu mohou pomoci při řešení řady Vašich problémů.
Dodáváme pivovarské kvasnice pro výrobu piva (vhodné pro pivovary, minipivovary i výrobu piva v domácích podmínkách). Pronajímáme prostory senzorické laboratoře s kompletním zázemím, kde se organizují spotřebitelské testy pro hodnocení potravin. Vydáváme online časopis Kvasný průmysl a řadu dalších publikací.
Poskytujeme poradenskou činnosti v oblasti technologií v pivovarství a sladařství, legislativy.
Více o našich službách na stránkách www.beerresearch.cz

.jpg?63e61ed1)